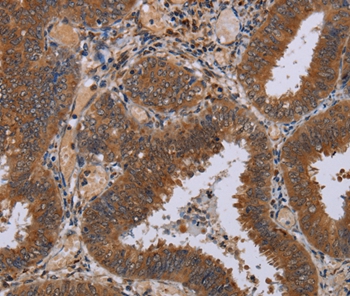

PathPlus(tm) NPTX1 Antibody
LS-B16387
ApplicationsELISA, ImmunoHistoChemistry, ImmunoHistoChemistry Paraffin
Product group Antibodies
ReactivityHuman, Mouse, Rat
TargetNPTX1
Overview
- SupplierLifeSpan BioSciences
- Product NamePathPlus(tm) NPTX1 Antibody
- Delivery Days Customer14
- ApplicationsELISA, ImmunoHistoChemistry, ImmunoHistoChemistry Paraffin
- Applications SupplierELISA, IHC-P (10 µg/ml)
- CertificationResearch Use Only
- ClonalityPolyclonal
- Concentration1 mg/ml
- ConjugateUnconjugated
- Estimated Purity...
- Gene ID4884
- Target nameNPTX1
- Target descriptionneuronal pentraxin 1
- Target synonymsNP1, SCA50, neuronal pentraxin-1, NP-I, neuronal pentraxin I
- HostRabbit
- IsotypeIgG
- ReactivityHuman, Mouse, Rat
- Storage Instruction-20°C
- UNSPSC12352203